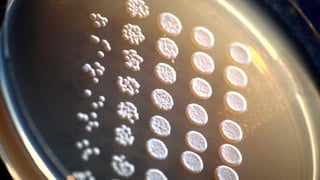

This document appears to be notes from a talk or presentation on the topics of artificial intelligence, machine learning, neuroscience, philosophy and ethics. It touches on concepts like sentience, sapience, biologically-inspired network design, personal identity, and discusses various thinkers and their works including Peter Singer, Daniel Dennett, and quotes from M. Scott Peck on love. Specific organizations or projects mentioned include Neurosynaptics, a company developing brain-inspired computing, and Nell Watson, an AI researcher.